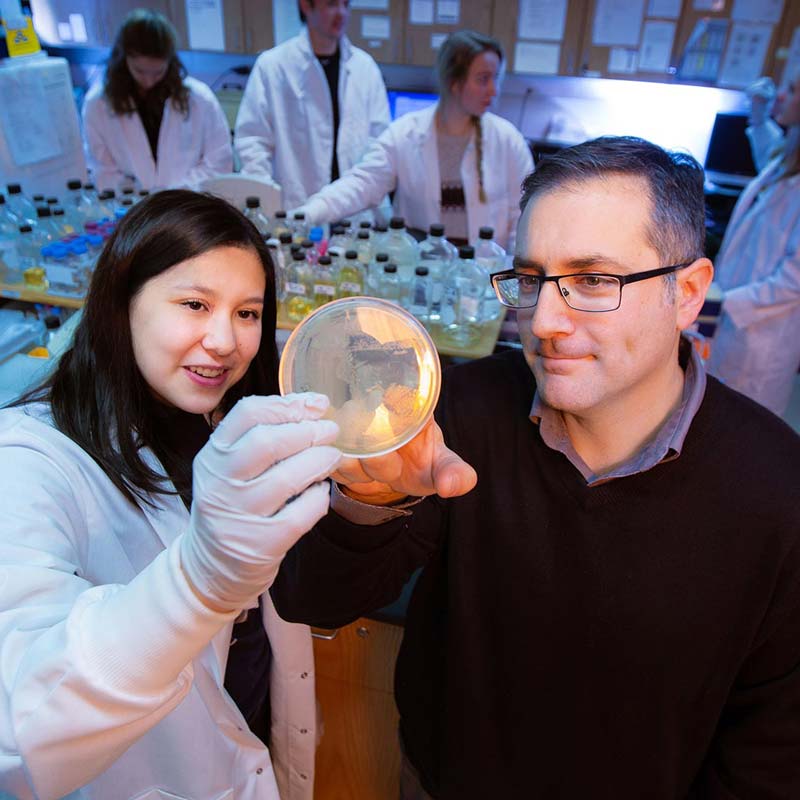
Biology research

Student Achievements
At Geneseo, we’re here to help you dream big. From caring professors who are invested in your future to clubs and organizations that lead you to your passion, we’re here to guide you through a journey of self-discovery and lead you to your best self. But don’t take it from us—take it from our students and graduates whose achievements reflect our College-wide commitment to student success.
Awards, Recognition, and Achievements
Below is a selection of some of the major honors, awards and recognition earned by students at SUNY Geneseo. This list, while impressive, is not comprehensive.